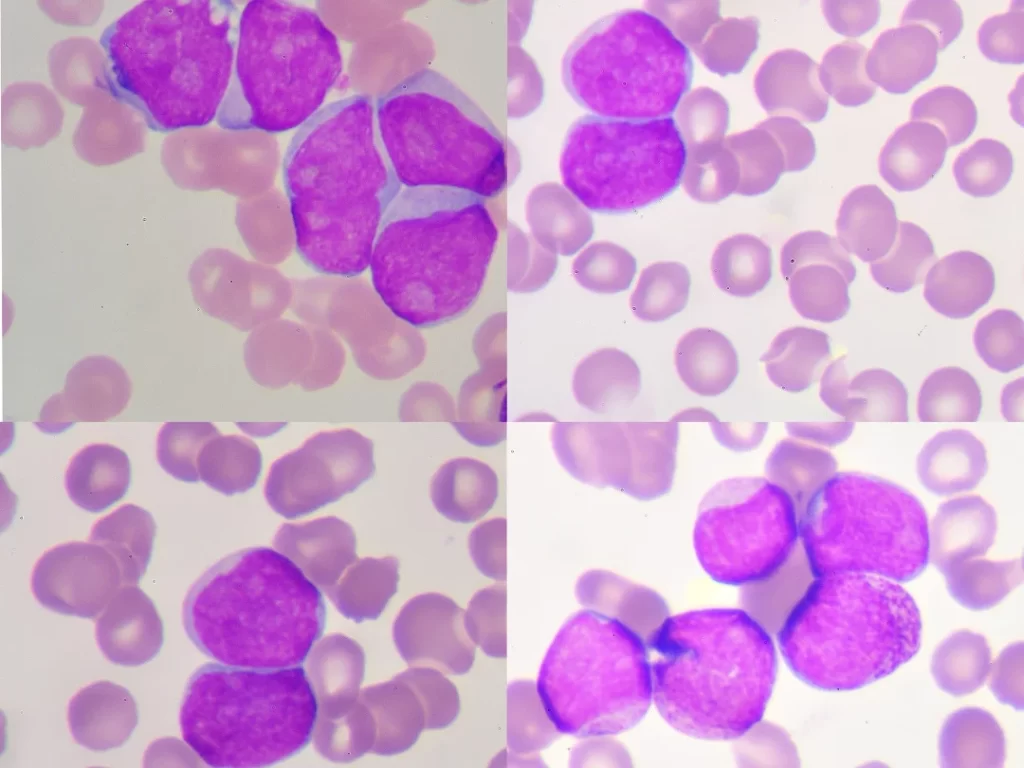

ÚLTIMOS DIA DE OFERTA COM ACESSO VITALÍCIO
Torne-se o Especialista em Hemograma Mais Requisitado do Seu Laboratório
Domine a interpretação completa do hemograma e destaque-se como referência em hematologia laboratorial

Certificado
40 horas

Acesso
Imediato

Acesso Vitalício

Garantia
7 dias

Uma nova era no ensino da hematologia
Prepare-se para uma experiência de aprendizado completamente reformulada, desenvolvida pelo renomado Prof. Dr. Luiz Arthur Calheiros – com mais de 20 anos de experiência e autor do Atlas do Sangue Periférico e Doenças Hematológicas.
Para quem é este curso? biomédicos, farmacêuticos, biólogos, médicos e estudantes dessas áreas, que desejam se aperfeiçoar em Hematologia.

Lâminas na Prática
Por que escolher o novo CHL?
- Metodologia testada e aprovada por mais de 7.000 alunos
- Professor referência nacional em Hematologia Laboratorial
- Conteúdo atualizado e prático para aplicação imediata
- Certificado de 40 horas
- Acesso Vitalício
O que você vai conquistar
- Domínio completo do hemograma em apenas 26 aulas objetivas e práticas
- Expertise em morfologia celular com treinamentos ao vivo
- Capacidade de identificar e interpretar casos complexos com confiança
- Reconhecimento como referência em seu laboratório
Seu professor será
- Fundador e Diretor da Escola Brasileira de Hematologia Laboratorial (LaHemato EaD);
- Autor do livro 'Atlas do Sangue Periférico e Doenças Hematológicas', Editora DEN (2019);
- Professor de Pós-Graduação Lato Sensu;
- Consultor em Hematologia Laboratorial com mais de 20 anos de experiência;
- Doutor em Bioquímica e Fisiologia pela Universidade Federal de Pernambuco (UFPE);
- Mestre em Hematologia, setor de Biologia Celular e Imunofenotipagem pela Universidade Federal de São Paulo (UNIFESP);
- Especialista em Hematologia e Hemoterapia pela Universidade Federal de São Paulo (UNIFESP);
- Proficiência Técnica em Laboratório de Hematologia pela Sociedade Brasileira de Hematologia e Hemoterapia (SBHH);
Bônus exclusivos por tempo limitado

Acesso aos 2 congressos em 2024 (JBPL e CBHL)
Disponibilizamos as gravações completas dos dois maiores congressos de 2024: o JBPL (Jornada Brasileira de Patologia do Laboratório) e o CBHL (Congresso Brasileiro de Hematologia e Laboratório)
de R$647 por R$0

12 cursos complementares
Treinamentos Práticos, Online e Ao Vivo, de Leitura de Lâminas e discussão de Casos Clínicos reais.
Estará de plantão? Tudo bem! Esses treinamentos também serão gravados e disponibilizados para você!
Com microscópio acoplado ao computador, você fará interpretações de diferentes Hemogramas junto com o professor!
de R$977 por R$0

Treinamentos práticos de morfologia ao vivo
Voltado para profissionais do laboratório, tanto de pequeno quanto de grande porte, incluindo biomédicos, farmacêuticos, biólogos e médicos, além de outros profissionais da área da saúde.
de R$447 por R$0

Suporte direto com o Professor 24/7 via WhatsApp
Participe do grupo exclusivo de alunos no WhatsApp e tire as dúvidas de seus casos e exames em tempo real, direto com o professor.
de R$247 por R$0
🎓 Primeiro encontro: 16/01/2025 Quinta-feira, 19h30
⚠️ Vagas Limitadas - As últimas turmas esgotaram em menos de 48 horas
⚡ OFERTA ESPECIAL - VÁLIDA ATÉ 31/01/2025!
de R$1297,00
por apenas
12x R$35,00
ou R$357 à vista

Garanta sua vaga agora mesmo

Formato revolucionário
- Aulas dinâmicas de 25-30 minutos para máxima absorção
- Encontros mensais ao vivo para análise de lâminas
- Módulos focados: anemia, leucócitos, plaquetas, leucemia aguda, neoplasias e mais
- Gravações em alta qualidade com equipamento profissional
Garantia total de 7 dias
Você adquire agora o acesso completo ao Curso de Hematologia Laboratorial na condição especial de R$357 e tem 7 dias para avaliar.
Se por algum motivo você achar que este material não é para você, ou que não vale o investimento, receberá seu dinheiro 100% de volta! Basta enviar uma mensagem para nós dentro do prazo de 7 dias.
Como você pode ver, o risco é todo nosso!

ATENÇÃO: Condição especial por tempo limitado!
Não perca a oportunidade de transformar sua carreira com o mais completo treinamento em Hematologia Laboratorial do Brasil.
*Oferta especial válida apenas até 31/01/2025 ou até esgotarem as vagas promocionais.

Conhecimento Hematológico ao Seu Alcance
fundada em 2019 pelo Prof. Dr. Luiz Arthur Calheiros Leite, a Escola Brasileira de Hematologia Laboratorial (LaHemato EaD) já compartilhou conhecimento com mais de 7.000 alunos do Brasil e exterior, em mais de 10 diferentes cursos da área laboratorial.
